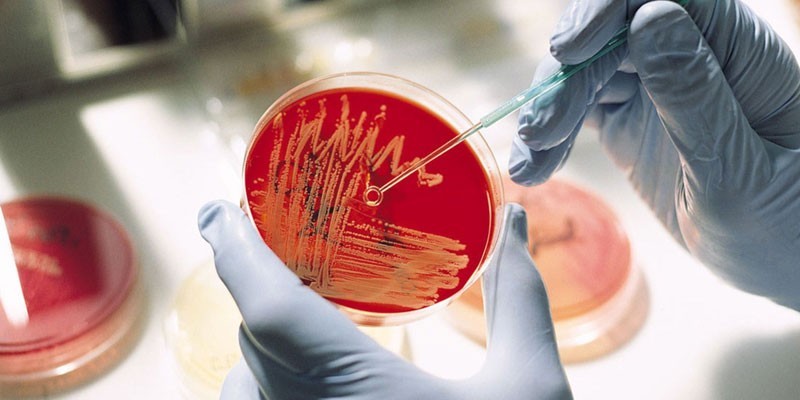
image

Псевдотуберкулез (дальневосточная скарлатиноподобная лихорадка) – это инфекционное заболевание из группы зоонозов, которое сопровождается скарлатиноподобной сыпью, интоксикационным синдромом, лихорадкой, мезентериальным лимфаденитом, симптомами поражения других органов. Возбудителем является Yersinia pseudotuberculosis.
Морфология возбудителя
Иерсиния псевдотуберкулеза является подвижной грамотрицательной овоидной палочкой размером 0,8х0,4 мкм из семейства Enterobacteriaceae, отличающаяся гетерогенностью. Бактерия имеет жгутики и капсулу, подвижна при температуре от 18 до 37° С. В своей антигенной структуре микроорганизм содержит 2 антигена – О (соматический) и Н (жгутиковый). Соматический антиген является специфичным – по нему возбудитель подразделяется на 10 серовариантов.

Мнение врача:
Возбудитель псевдотуберкулеза, или Микобактерия фарингеальная, представляет собой грамотрицательные, неподвижные, аэробные палочковидные бактерии. Морфологически они имеют форму клубка или цепочки, окрашиваются по методу Цил-Нильсена. Культуральные свойства включают медленный рост на питательных средах, образование кремовых или желтоватых колоний. Патогенные свойства микроорганизма проявляются в способности вызывать воспалительные процессы в организме, в частности, в области дыхательных путей. Мнение врачей подтверждает важность изучения данного возбудителя для своевременной диагностики и лечения заболеваний, вызванных им.

Культуральные свойства
Бактерия не имеет особых требований к питательным средам и растет даже на обедненных средах без органических и азотосодержащих веществ, в том числе при низких температурах 4–8 °С. Иерсиния псевдотуберкулеза относится к факультативным анаэробам. Оптимальная кислотность составляет 6–8, а температура 28–30 °С. При культивировании на разных средах вырастают S и R формы колоний.
Интересные факты
-
Возбудитель псевдотуберкулеза, Yersinia pseudotuberculosis, является грам-отрицательной бактерией из семейства Yersiniaceae. Он морфологически схож с возбудителем туберкулеза, Mycobacterium tuberculosis, отсюда и получил свое название. Yersinia pseudotuberculosis имеет форму палочки, размером от 0,5 до 3 микрон в длину и от 0,2 до 0,5 микрон в ширину. Она подвижна, имеет полярно расположенные жгутики и может образовывать биопленки.
-
Возбудитель псевдотуберкулеза широко распространен в окружающей среде. Его можно обнаружить в почве, воде, сточных водах, продуктах питания животного и растительного происхождения. Основным резервуаром инфекции являются грызуны, особенно мыши и крысы. Передача инфекции от животных к человеку может происходить через контакт с зараженными поверхностями, водой или пищей.
-
Возбудитель псевдотуберкулеза обладает разными факторами патогенности, которые включают устойчивость к кислой среде желудка, способность проникать через слизистые оболочки, адгезины и токсины. Эта бактерия может вызывать различные заболевания у человека, включая пищевое отравление, диарею, мезентериальный лимфаденит, псевдотуберкулезный абсцесс печени, сепсис и менингит. Симптомы заболевания могут включать тошноту, рвоту, диарею, боли в животе, увеличение лимфатических узлов, лихорадку и озноб.

Патогенные свойства
Yersinia pseudotuberculosis более вирулентна, чем другие виды иерсиний. Микроорганизм имеет термостабильный эндотоксин, а некоторые его сероварианты способны к синтезу экзотоксина. Распространение микроорганизма за пределы кишечника сопровождается бактериемией, которая характеризуется бактериально-токсическим поражением других систем организма. Преимущественный путь передачи бактерий – алиментарный с фекально-оральным механизмом, возможно заражение водным или контактным путем. Источники инфекции:
- вода;
- кошки;
- крупный рогатый скот;
- грызуны;
- испражнения;
- овцы;
- олени;
- почва;
- птицы;
- свиньи;
- собаки.

Опыт других людей
Возбудитель псевдотуберкулеза, известный как Mycobacterium kansasii, вызывает обсуждения среди специалистов и пациентов. Этот микроорганизм имеет особую морфологию, культуральные и патогенные свойства, что делает его объектом внимания в медицинской сфере. Люди выражают разные мнения о нем, исходя из своего опыта и знаний. Одни обсуждают его роль в возникновении заболеваний, другие делятся методами борьбы с ним. Обсуждения вокруг возбудителя псевдотуберкулеза продолжаются, и каждый вносит свой вклад в изучение этого микроорганизма.
Видео
Внимание!
Информация, представленная в статье, носит ознакомительный характер. Материалы статьи не призывают к самостоятельному лечению. Только квалифицированный врач может поставить диагноз и дать рекомендации по лечению, исходя из индивидуальных особенностей конкретного пациента.
Частые вопросы
Что характерно для псевдотуберкулеза?
Симптомы псевдотуберкулеза Для всех форм псевдотуберкулеза характерно острое начало заболевания, повышение температуры тела до 38-40°С и симптомы общей интоксикации разной степени выраженности: головная боль, общая слабость, отсутствие аппетита, боли в костях, мышцах, суставах и т. п.
Кто вызывает псевдотуберкулез?
При псевдотуберкулезе основными источниками инфекции являются синантропные и дикие грызуны. Человек, как правило, источником псевдотуберкулеза не является. Основной путь распространения обеих инфекций – пищевой.
Что за болезнь Псевдотуберкулёз?
Псевдотуберкулез – инфекционное заболевание, характеризующееся разнообразием клинических проявлений: интоксикация, лихорадка, поражение желудочно-кишечного тракта, печени, кожи, опорно-двигательного аппарата и других органов. Возбудитель заболевания – бактерия Yersinia pseudotuberculosis.
Какой путь передачи характерен для псевдотуберкулеза?
Pseudotuberculosis) (дальневосточная скарлатиноподобная лихорадка, иерсиниоз) — острое инфекционное сапрозоонозное заболевание, характеризующееся лихорадкой, интоксикацией, поражением тонкого кишечника, печени, нередко скарлатиноподобной сыпью. Основной путь заражения — алиментарный (с пищей).
Полезные советы
СОВЕТ №1
При изучении возбудителя псевдотуберкулеза обратите внимание на его морфологию, особенности культуральных свойств и патогенные особенности, чтобы получить полное представление о микроорганизме.
СОВЕТ №2
Изучите литературу и научные статьи, посвященные данной теме, чтобы получить дополнительные сведения о возбудителе псевдотуберкулеза и его свойствах.







